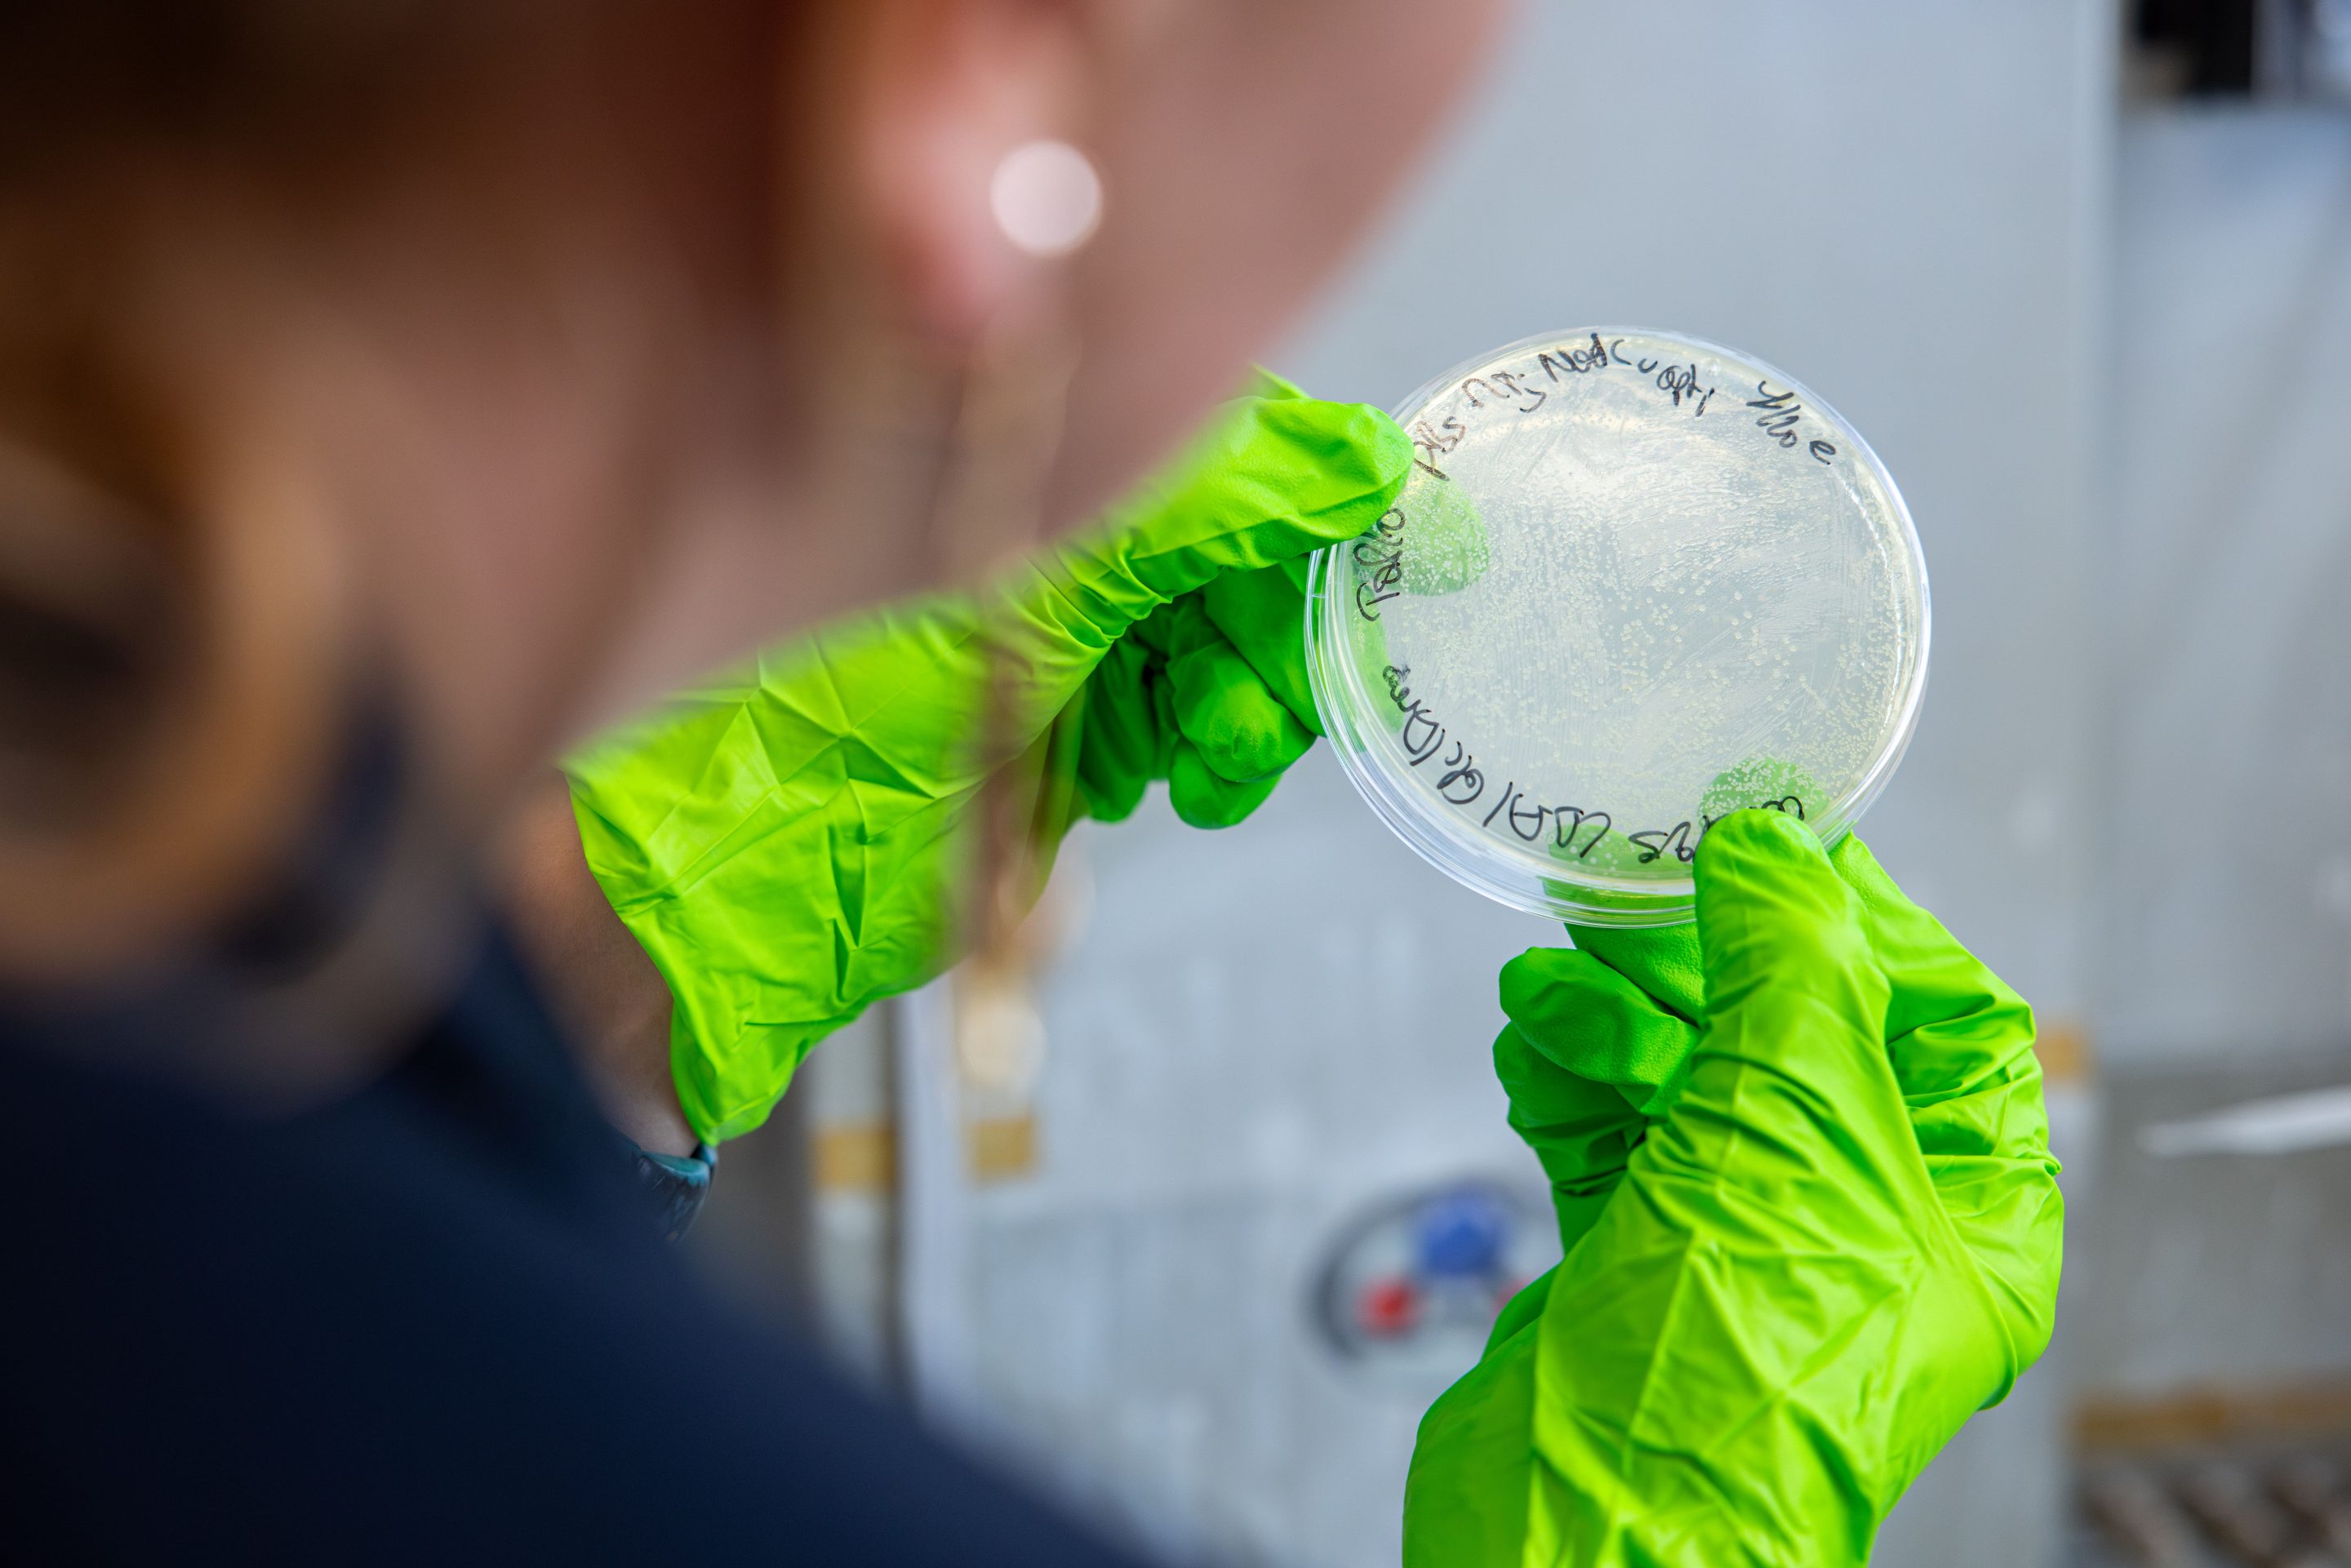
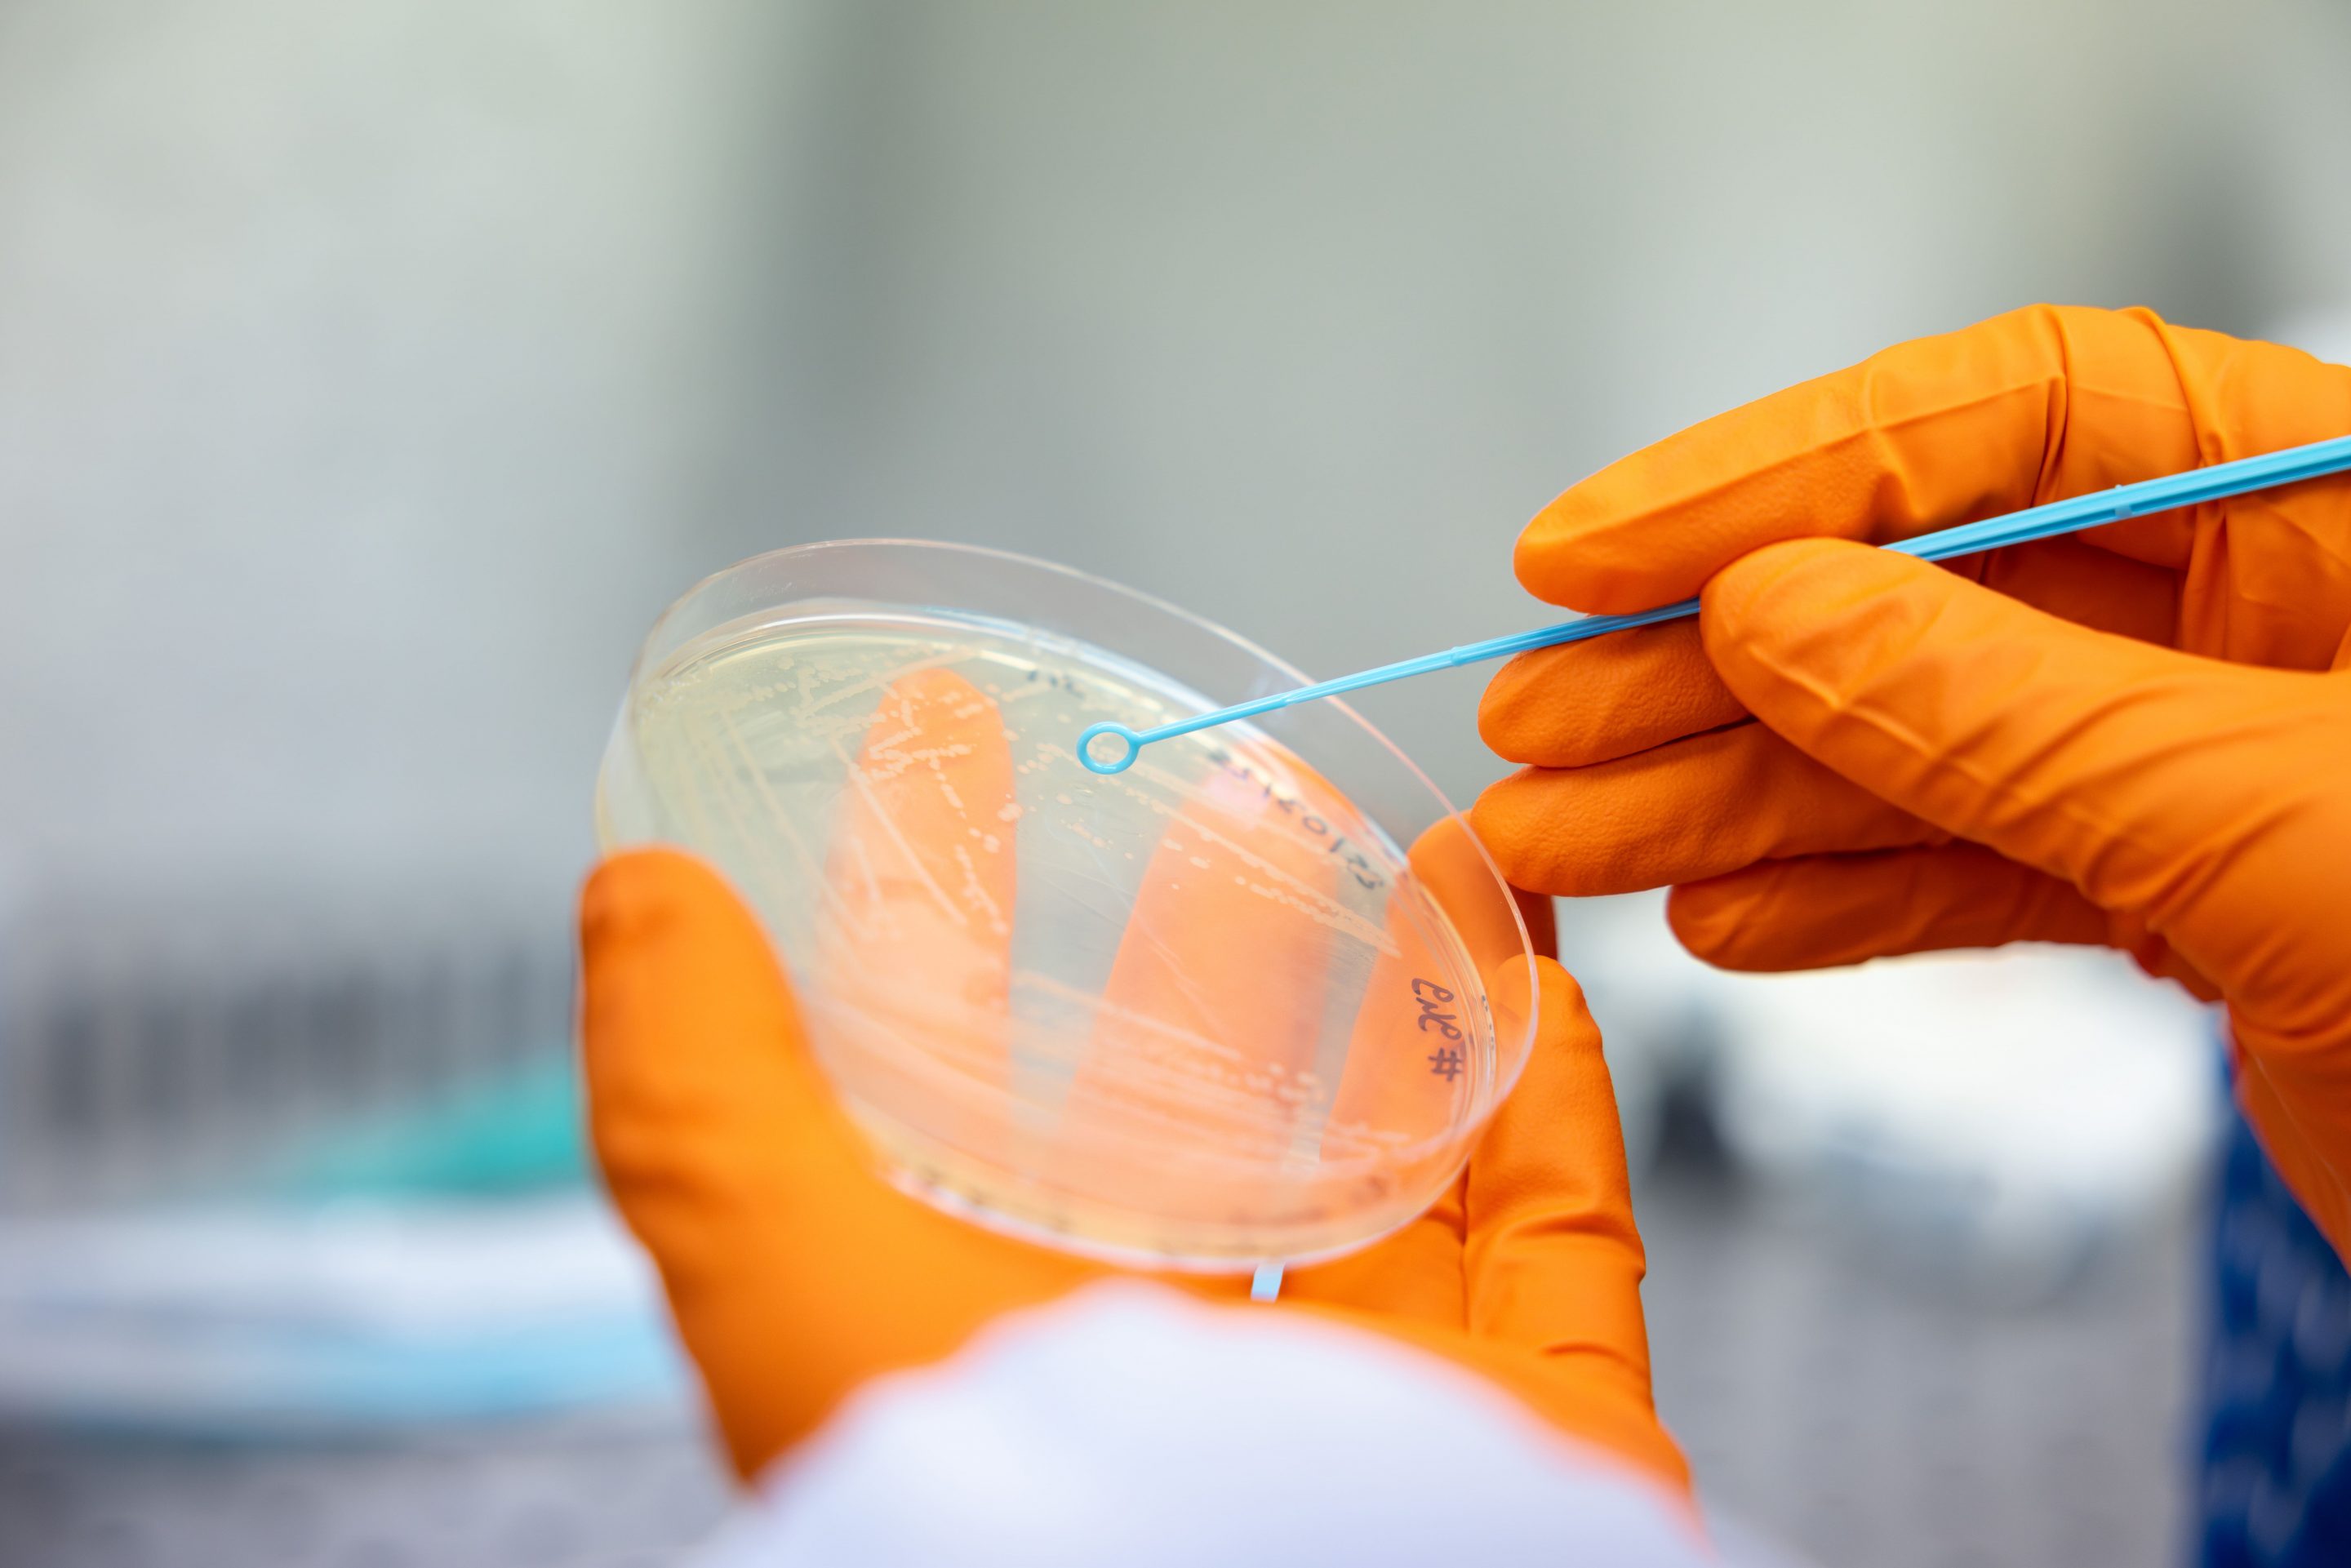

Présenter votre structure
Pourquoi présenter votre structure
en photo et vidéo ?
Dans un monde saturé d’offres et d’informations, montrer qui vous êtes est devenu essentiel.
La photo institutionnelle et la vidéo de présentation permettent à votre structure d’être visible, reconnaissable, humaine.
Peu importe la qualité de vos services ou produits : si personne ne les connaît, ils n’existent pas aux yeux de vos prospects. Intégrer des contenus visuels dans votre communication externe, c’est :
➤ Renforcer votre crédibilité auprès de vos futurs clients et partenaires.
➤ Humaniser votre image en montrant vos équipes, vos gestes, votre environnement.
➤ Booster l’engagement grâce à des formats courts, visuels et dynamiques.
➤ Asseoir votre différenciation par une esthétique et un discours visuel sur mesure.
Un geste, un lieu, une ambiance… autant d’éléments qui donnent envie de vous faire confiance.

Quelle différence entre
photo institutionnelle et vidéo de présentation ?
La photo institutionnelle
est la base solide de votre
communication visuelle :
- Montrer vos savoir-faire,
vos locaux, vos équipes. - Offrir de la transparence
à vos parties prenantes. - Créer un stock d’images professionnelles utilisables sur tous vos supports.
La vidéo de présentation
permet de raconter
votre histoire :
- Valoriser votre mission, vos engagements, votre énergie collective.
- Mettre en scène vos différents
savoir-faire de manière dynamique. - Impliquer vos équipes dans une démarche valorisante
« Ces deux formats sont complémentaires :
là où la photo fige l’essentiel,
la vidéo incarne votre dynamisme. »
Diffuser stratégiquement

Sur vos
réseaux sociaux :Pour animer vos communautés
et augmenter votre visibilité.

Sur votre
site internet :Accueil, pages
« Qui sommes-nous »,
recrutement, actualités.

Dans vos
outils commerciaux :Présentations clients,
salons professionnels, appels d’offres.

En interne :
Pour renforcer
la fierté d’appartenance
et l’engagement collaborateur.
« Une image forte ou une vidéo bien construite
deviennent vos alliés les plus efficaces
pour incarner votre message. »
Un peu d’inspiration
50 ans de l’association
Présentation vidéo d’association
Présentation de l’hébergement
Photos tourisme
Présentation du salon
Présentation vidéo d’entreprise
Présentation de l’hébergement
Photos tourisme
Photos portraits de dirigeants
Photos professionnelles
Photos présentation
Dans les coulisses du CHU
Présentation vidéo d’institution
Présentation de l’entreprise
Présentation photos d’entreprise
Présentation de la structure
Présentation vidéo de l’association
Présentation de la pizzeria
Présentation vidéo d’entreprise
Photos portraits de dirigeants
Photos professionnelles
Photos présentation
Réalisations Immobilières Iséroises
Présentation vidéo d’association
Présentation de l’entreprise
Présentation photos d’entreprise
Présentation de la structure
Présentation vidéo de l’entreprise
Présentation de la start-up
Photos de présentation
Photos portraits de dirigeants
Photos professionnelles
Photos présentation
Présenter votre
structure avec les Witty,
ça ressemble à quoi ?

- 9Définition précise de votre image afin de vrailent impacter votre cible.
- 9Sélection des lieux, angles et lumières les plus porteurs pour créer votre identité.
- 9Coaching léger des intervenant·e·s pour des prises naturelles.
- 9Storyboard clair pour organiser la fluidité du tournage ou shooting.
- 9Travail de montage pour refléter votre ADN (non formaté).
- 9Livraison de visuels optimisés pour site web, supports, réseaux.
« Prêt·e·s à faire rayonner votre structure ?«
Chaque image et chaque vidéo doivent être un écho juste de qui vous êtes.
Contactez-nous pour construire ensemble des contenus
qui donnent envie de vous découvrir et de vous rejoindre.
Processus de réalisation d’un projet

Valorisez votre entreprise grâce
à nos contenus dediés à votre communication interne.